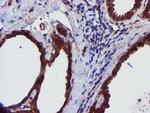
EPN2 Antibody in Immunohistochemistry (Paraffin) (IHC (P))

Search
OriGene
EPN2 Monoclonal Antibody (OTI1F1), TrueMAB™
{{$productOrderCtrl.translations['antibody.pdp.commerceCard.promotion.promotions']}}
{{$productOrderCtrl.translations['antibody.pdp.commerceCard.promotion.viewpromo']}}
{{$productOrderCtrl.translations['antibody.pdp.commerceCard.promotion.promocode']}}: {{promo.promoCode}} {{promo.promoTitle}} {{promo.promoDescription}}. {{$productOrderCtrl.translations['antibody.pdp.commerceCard.promotion.learnmore']}}
产品信息
TA504298
种属反应
宿主/亚型
分类
类型
克隆号
抗原
偶联物
形式
浓度
纯化类型
保存液
内含物
保存条件
运输条件
靶标信息
Epsin2 plays a role in the formation of clathrin-coated invaginations and endocytosis. It binds to EPS15 (via the NPF repeat domain), as well as to AP-2 and clathrin (via the DPW repeat domain). The protein resides in the cytoplasm, in punctate structures throughout the cell, associated with clathrin-coated vesicles, and is particularly concentrated in the region of the Golgi complex. Highest expression is found in brain, with lower levels detected in lung and liver.
仅用于科研。不用于诊断过程。未经明确授权不得转售。
篇参考文献 (0)
生物信息学
蛋白别名: EPS-15-interacting protein 2; Eps15 binding protein; Epsin-2
基因别名: EHB21; EPN2; KIAA1065
UniProt ID: (Human) O95208
Entrez Gene ID: (Human) 22905